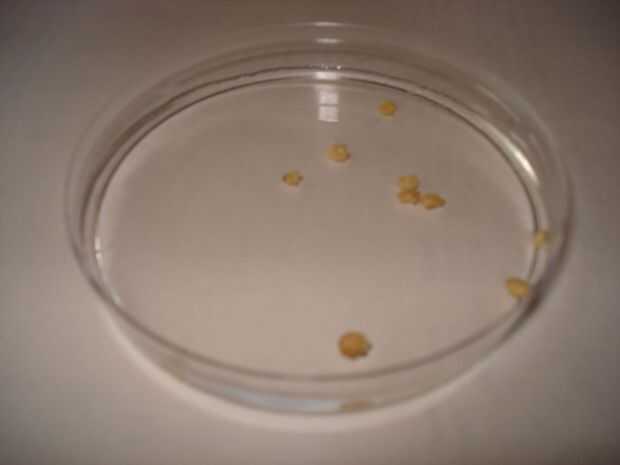

Paso 4: Preparación de las semillas / despensa de las semillas
Una vez que las semillas son hidratadas, no debemos olvidar que no son estériles y pueden también contaminan nuestro medio, por lo que debemos tratar en primer lugar. Para ello, quitar el agua y verter en su lugar, sobre las semillas, 3 peróxido de 10 volúmenes (o %). Debemos mantenerlos en este líquido durante unos 15 minutos y entonces estamos listos para sembrar!
Antes de sembrar, debemos Donalda las semillas. Si las compramos, vienen secas, por lo tenemos hidratarlas primero. Yo lo hice colocándolas en una placa de petri con horas de agua por aproximadamente dos. Si no tienen una placa de petri no importa, no es necessária, yo las usan porque las tenía y me resultan cómodas.
Luego de las semillas están hidratadas, no debemos olvidar que no son estériles y también pueden tener algo contamine nuestro medio, por lo debemos tratarlas primero. Para hacer esto, tiramos el agua y las colocamos en agua oxigenada al 3% (o 10 volúmenes). Debemos mantenerlas en este líquido por aproximadamente 15 minutos y colapsarla estamos amarillo para sembrar!